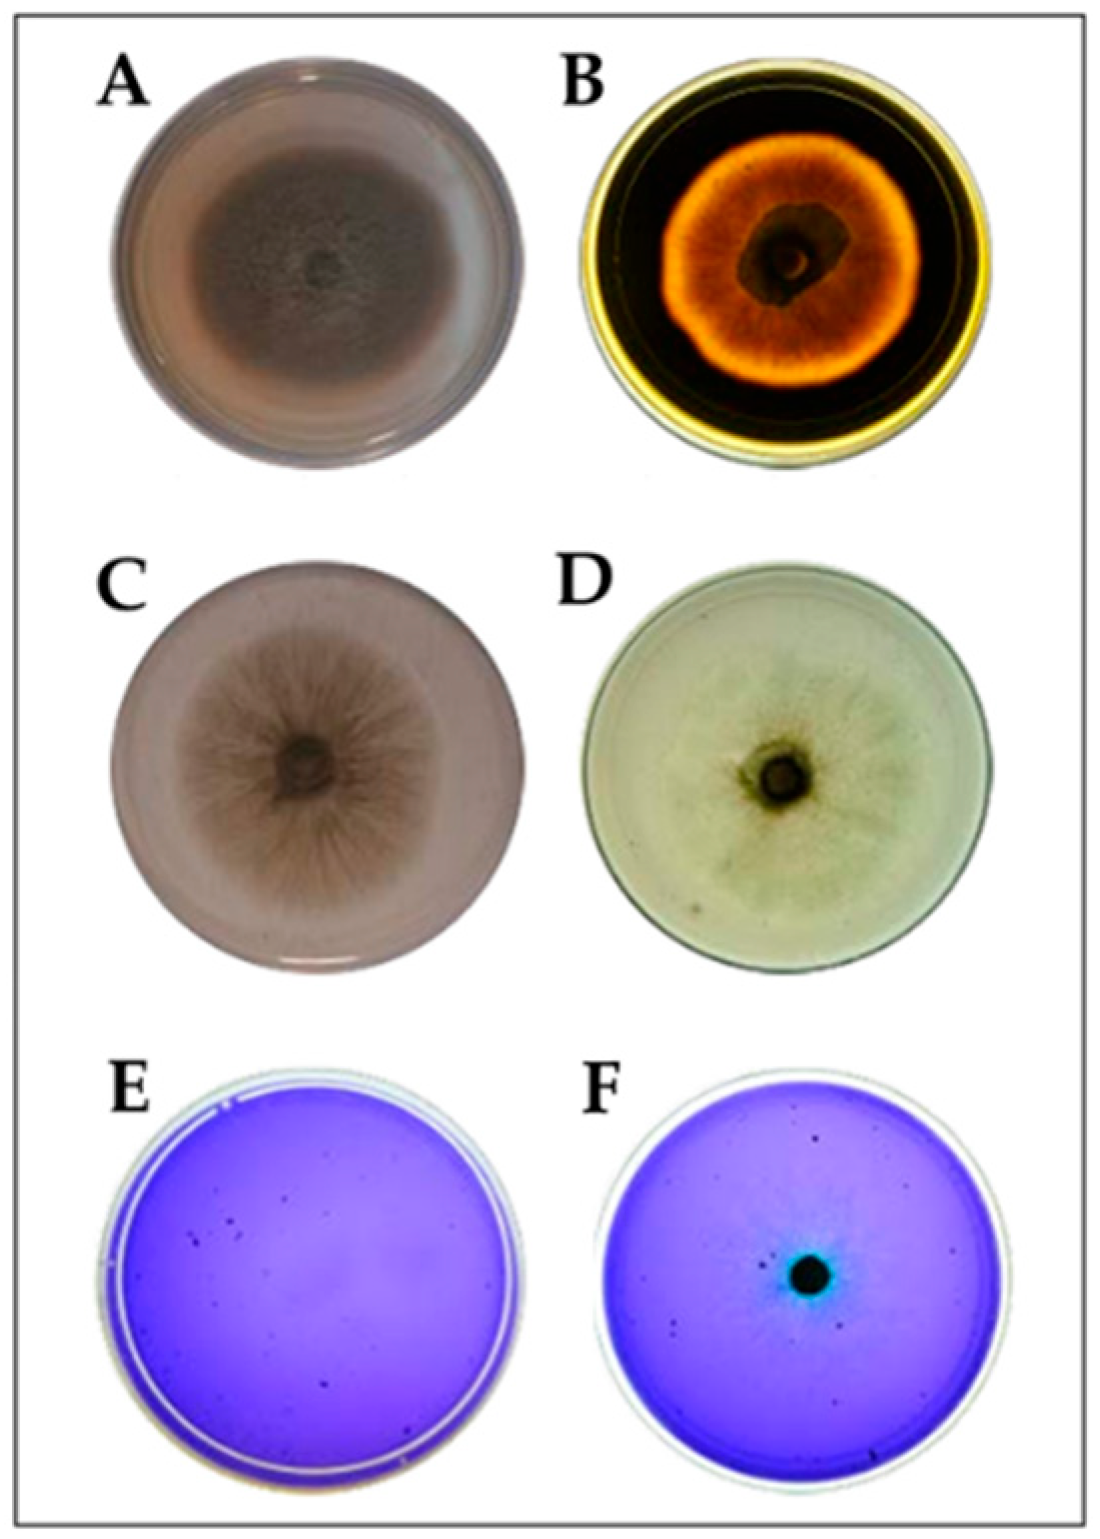
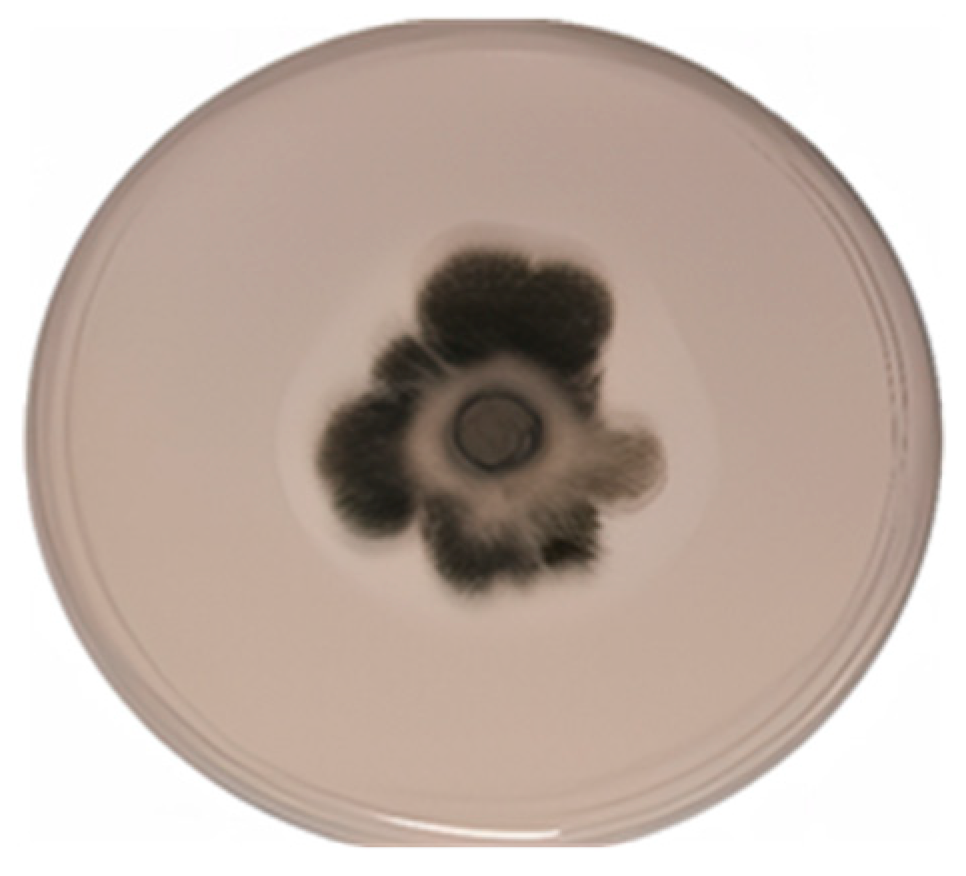

Can the DSE Fungus Exserohilum rostratum Mitigate the Effect of Salinity on the Grass Chloris gayana?
Abstract
1. Introduction
2. Material and Methods
2.1. Isolation of DSE Fungi from Chloris Gayana Roots and Taxonomic Identification
2.2. Fungal Characterization
2.2.1. Salinity Tolerance
2.2.2. Enzyme Activity
2.2.3. Medium Acidification Capacity
2.2.4. Phosphate Solubilization Capacity
2.2.5. Root Colonization
2.3. Greenhouse Experiments and Plant Analyses
2.3.1. Fungal Inoculation
2.3.2. Plant Growth and Physiological Measurements
2.4. Statistical Analysis
3. Results
3.1. Fungus Response to Salinity
3.2. Response of Chloris Gayana to Salinity and Fungus Inoculation
3.3. Effect of the Fungi on Grass Tolerance to Salinity
4. Discussion
5. Conclusions
Supplementary Materials
Author Contributions
Funding
Data Availability Statement
Conflicts of Interest
References
- Mandyam, K.; Jumpponen, A. Seeking the elusive function of the root-colonising dark septate endophytic fungi. Stud. Mycol. 2005, 53, 173–189. [Google Scholar] [CrossRef]
- Santos, S.G.D.; Silva, P.R.A.D.; García, A.C.; Zilli, J.E.; Berbara, R.L. Dark septate endophyte decreases stress on rice plants. Braz. J. Microbiol. 2017, 48, 333–341. [Google Scholar] [CrossRef]
- Ren, Y.; Bi, Y.; Kang, J. The overlooked salt: Impact of dark septate endophytes on alfalfa at varying sodium sulfate levels. Rhizosphere 2024, 32, 100987. [Google Scholar] [CrossRef]
- Yadav, S.; Atri, N. Impact of Salinity Stress in Crop Plants and Mitigation Strategies. In New Frontiers in Stress Management for Durable Agriculture; Amitava, R., Sing, H.B., Singh, A.K., Singh, U.S., Fraceto, L., Eds.; Springer Nature: Singapore, 2020; pp. 49–64. [Google Scholar]
- Haj-Amor, Z.; Araya, T.; Kim, D.G.; Bouri, S.; Lee, J.; Ghiloufi, W.; Yang, Y.; Kang, H.; Kumar Jhariya, M.; Banerjee, A.; et al. Soil salinity and its associated effects on soil microorganisms, greenhouse gas emissions, crop yield, biodiversity and desertification: A review. Sci. Total Environ. 2022, 843, 156946. [Google Scholar] [CrossRef]
- Kaya, C.; Ashraf, M.; Sonmez, O.; Aydemir, S.; Levent Tuna, A.; Cullu, M.A. The influence of arbuscular mycorrhizal colonisation on key growth parameters and fruit yield of pepper plants grown at high salinity. Sci. Hortic. 2009, 121, 1–6. [Google Scholar] [CrossRef]
- Macauley, B.J.; Griffin, D.M. Effect of carbon dioxide and the bicarbonate ion on the growth of some soil fungi. Trans. Br. Mycol. Soc. 1969, 53, 223–228. [Google Scholar] [CrossRef]
- Tang, M.; Sheng, M.; Chen, H.; Zhang, F.F. In vitro salinity resistance of three ectomycorrhizal fungi. Soil Biol. Biochem. 2009, 41, 948–953. [Google Scholar] [CrossRef]
- Gaber, D.A.; Berthelot, C.; Blaudez, D.; Kovács, G.M.; Franken, P. Impact of dark septate endophytes on salt stress alleviation of tomato plants. Front. Microbiol. 2023, 14, 1124879. [Google Scholar] [CrossRef]
- Tan, J.Y.; Yue, Z.C.; Li, S.T.; Pan, Y.Y.; Chu, Z.Y.; Ban, Y.H.; Xu, Z.Y. Alleviation of Salt Stress and Changes in Glycyrrhizic Acid Accumulation by Dark Septate Endophytes in Glycyrrhiza glabra Grown under Salt Stress. J. Agric. Food Chem. 2024, 72, 14557–14569. [Google Scholar] [CrossRef]
- Miranssari, M. Arbuscular mycorrhizal fungi and nitrogen uptake. Review article. Arch. Microbiol 2011, 193, 77–81. [Google Scholar] [CrossRef]
- Liu, Z.; Shang, H.; Han, F.; Zhang, M.; Li, Q.; Zhou, W. Improvement of nitrogen and phosphorus availability by Pseudoalteromonas sp. during salt-washing in saline-alkali soil. Appl. Soil Ecol. 2021, 168, 104117. [Google Scholar] [CrossRef]
- Silva, L.I.D.; Pereira, M.C.; Carvalho, A.M.X.D.; Buttrós, V.H.; Pasqual, M.; Dória, J. Phosphorus-solubilizing microorganisms: A key to sustainable agriculture. Agriculture 2023, 13, 462. [Google Scholar] [CrossRef]
- Newsham, K.K. A meta–analysis of plant responses to dark septate endophytes. New Phytol. 2011, 10, 783–793. [Google Scholar] [CrossRef]
- Imbellone, P.A.; Taboada, M.A.; Damiano, F.; Lavado, R.S. Genesis, properties and management of salt-affected soils in the Flooding Pampas, Argentina. In Saline and Alkaline soils in Latin America: Natural Resources, Management and Productive Alternatives; Taleisnik, E., Lavado, R.S., Eds.; Springer Nature: Cham, Suizerland, 2020; pp. 191–208. [Google Scholar]
- Daba, A.W.; Qureshi, A.S.; Nisaren, B.N. Evaluation of Some Rhodes Grass (Chloris gayana) Genotypes for Their Salt Tolerance, Biomass Yield and Nutrient Composition. Appl. Sci. 2019, 9, 143. [Google Scholar] [CrossRef]
- Marcum, K.B. Salinity tolerance mechanisms of grasses in the subfamily Chloridoideae. Crop Sci. 1999, 39, 1153–1160. [Google Scholar] [CrossRef]
- Pérez, H.; Bravo, S.; Ongaro, V.; Castagnaro, A.; García Seffino, L.; Taleisnik, E. Chloris gayana cultivars: RAPD polymorphism and field perfomance under salinity. Grass Forage Sci. 1999, 54, 289–296. [Google Scholar] [CrossRef]
- Tao, R.; Ding, J.; Li, C.; Zhu, X.; Guo, W.; Zhu, M. Evaluating and Screening of Agro-Physiological Indices for Salinity Stress Tolerance in Wheat at the Seedling Stage. Front. Plant Sci. 2021, 12, 12. [Google Scholar] [CrossRef]
- Taleisnik, E.; Peyrano, G.; Arias, C. Response of Chloris gayana cultivars to salinity. 1. Germination and early vegetative growth. Trop. Grassl. 1997, 31, 232–240. [Google Scholar]
- Pandey, B.R.; Puri, R.R.; Shunmugam, A.S.K.; Noy, D.; Rosewarne, G.M. Association of seedling vigour and salinity tolerance in field pea. Plants 2024, 3, 3140. [Google Scholar] [CrossRef]
- Fedeli, R.; Vannini, A.; Djatouf, N.; Celletti, S.; Loppi, S. Can lettuce plants grow in saline soils supplemented with biochar? Heliyon 2024, 10, e26526. [Google Scholar] [CrossRef]
- Barbosa, O.A.; Álvarez-Rogel, J.; Lavado, R.S. Forage offer from a saline wetland of central Argentina (San Luis province). Wetl. Ecol. Manag. 2023, 32, 703–712. [Google Scholar] [CrossRef]
- Pérez-López, A.V.; Sung, D.L.; Cushman, J.C. Humboldt Review: Tissue succulence in plants: Carrying water for climate change. J. Plant Physiol. 2023, 289, 154081. [Google Scholar] [CrossRef]
- Nleya, T.; Clay, S.A.; Perkins, L.; Mertz, C. Plant Reponses to Salt Stress. In Salinity and Sodicity, A Global Challenge to Food Security, Environmental Quality, and Soil Resilience; Clay, D.E., DeSutter, T.M., Clay, S.A., Nleya, T., Eds.; ASA: Monroe, MI, USA; CSSA; SSSA: Madison, WI, USA; Wiley & Sons, Inc.: Hoboken, NJ, USA, 2024; pp. 73–83. [Google Scholar]
- Oi, T.; Clode, P.I. Taniguchi, M.; Colmer, T.D.; Kotula, L. Salt tolerance in relation to elemental concentrations in leaf cell vacuoles and chloroplasts of a C4 monocotyledonous halophyte. Plant Cell Environ. 2022, 45, 1490–1506. [Google Scholar] [CrossRef]
- Abu-Alrub, I.; Marcum, K.B.; Kabirl, N.; Aran, A.; Al Hammadi, A. Productivity and nutritional value of four forage grass cultivars compared to Rhodes grass irrigated with saline water. Australian J. Crop Sci. 2018, 12, 203–209. [Google Scholar] [CrossRef]
- Assaha, D.V.; Ueda, A.; Saneoka, H.; Al-Yahyai, R.; Yaish, M.W. The role of Na+ and K+ transporters in salt stress adaptation in glycophytes. Front. Physiol. 2017, 8, 509. [Google Scholar] [CrossRef]
- Almeida, D.M.; Oliveira, M.M.; Saibo, N.J. Regulation of Na+ and K+ homeostasis in plants: Towards improved salt stress tolerance in crop plants. Genet. Mol. Biol. 2017, 40 (Suppl. S1), 326–345. [Google Scholar] [CrossRef] [PubMed]
- Spagnoletti, F.N.; Tobar, N.E.; Fernández Di Pardo, A.; Chiocchio, V.M.; Lavado, R.S. Dark septate endophytes present different potential to solubilize calcium, iron and aluminum phosphates. Appl. Soil Ecol. 2017, 111, 26–32. [Google Scholar] [CrossRef]
- Sarkar, D.; Haldar, A. Physical and Chemical Methods in Soil Analysis; New Age International Publishers: New Delhi, India, 2023. [Google Scholar]
- Levin, L.; Papinutti, L.; Forchiassin, F. Evaluation of Argentinean White rot fungi for their ability to produce lignin-modifying enzymes and decolorize industrial dyes. Bioresour. Technol. 2004, 94, 169–176. [Google Scholar] [CrossRef]
- Pandey, A.; Das, N.; Kumar, B.; Rinu, K.; Trivedi, P. Phosphate solubilization by Penicillium spp. isolated from soil samples of Indian Himalayan region. World J. Microbiol. Biotechnol 2008, 24, 97–102. [Google Scholar] [CrossRef]
- Soni, S.K.; Singh, R.; Ngpoore, N.K.; Niranjan, A.; Singh, P.; Mishra, A.; Tiwari, S. Isolation and characterization of endophytic fungi having plant growth promotion traits that biosynthesizes bacosides and withanolides under in vitro conditions. Brazilian J. Microbiol. 2021, 52, 1791–1805. [Google Scholar] [CrossRef]
- Barrow, J.R.; Aaltonen, R.E. Evaluation of the internal colonization of Atriplex canescens (Pursh) Nutt. roots by dark septate fungi and the influence of host physiological activity. Mycorrhiza 2001, 11, 199–205. [Google Scholar] [CrossRef]
- Kalita, U.; Sanyasi, M.; Kumari, P.; Baidya, A. Fungal Biostimulants. Sustainable tool to boost crop yield naturally. In Mycological Inventions for Sustainable Agriculture and Food Production; IGI Global: Hershey, PA, USA, 2025; pp. 97–130. [Google Scholar] [CrossRef]
- Bauer, P.J.; Stone, K.C.; Foulk, J.A.; Dodd, R.B. Nitrogen, Phosphorus, Potassium, Calcium, Magnesium, and Zinc in Southeastern USA Harvested Flax. Crop Forage Turfgrass Manag. 2015, 1, 1–5. [Google Scholar] [CrossRef]
- Undersander, D.J. Forage Analyses Procedures; National Forage Testing Association: Madison, WI, USA, 2011; p. 154. [Google Scholar]
- Mc Gonigle, T.P.; Miller, M.H.; Evans, D.G.; Fairchild, G.L.; Swan, J.A. A new method which gives an objective measure of colonization of root by vesicular-arbuscular fungi. New Phytol. 1990, 115, 495–501. [Google Scholar] [CrossRef]
- Ruotsalainen, A.L.; Kytöviita, M.M. Mycorrhiza does not alter low temperature impact on Gnaphalium norvegicum. Oecologia 2004, 140, 226–233. [Google Scholar] [CrossRef]
- Mandyam, K. Dark Septate Fungal Endophytes from a Tallgrass Prairie and Their Continuum of Interactions with Host Plants. Ph.D. Thesis, Kansas State University, Manhattan, KS, USA, 2008. [Google Scholar]
- Mayerhofer, M.S.; Kernaghan, G.; Harper, K.A. The effects of fungal root endophytes on plant growth a meta-analysis. Mycorrhiza 2012, 3, 119–128. [Google Scholar] [CrossRef]
- Peterson, R.L.; Wagg, C.; Pautler, M. Associations between microfungal endophytes and roots: Do structural features indicate function? Can. J. Bot. 2008, 86, 445–456. [Google Scholar] [CrossRef]
- Toghueo, R.M.K.; Zabalgogeazcoa, I.; Pereira, E.C.; Aldana, B.R.V. A Diaporthe Fungal Endophyte from a Wild Grass Improves Growth and Salinity Tolerance of Tritordeum and Perennial Ryegrass. Front. Plant Sci. 2022, 13, 896755. [Google Scholar] [CrossRef]
- Zhao, D.; Gao, S.; Zhang, X.; Zhang, Z.; Zheng, H.; Rong, K.; Zhao, W. Impact of saline stress on the uptake of various macro and micronutrients and their associations with plant biomass and root traits in wheat. Plant Soil Environ. 2021, 67, 61–70. [Google Scholar] [CrossRef]
- Jarrell, W.M.; Beverly, R.B. The dilution effect in plant nutrition studies. Adv. Agron. 1981, 34, 197–224. [Google Scholar]
- Otondo, J.; Borrajo, C.; Banderas, R. Forr.ajeras templadas y subtropicales en suelos afectados por sales de regiones húmedas y subhúmedas de la República Argentina. In Ambientes Salinos y Alcalinos de la Argentina: Recursos y Aprovechamiento Productivo; Taleisnik, E., Lavado, R.S., Eds.; FCA-UCC y OGE: Buenos Aires, Argentina, 2017; pp. 295–323. [Google Scholar]

| Solution Na Concentration | Fungal Biomass (g) | Na Accumulation (mgNa/g Dry Mycelium) |
|---|---|---|
| Control | 0.32 ± 0.07 b | 0.020 ± 0.007 a |
| 10 meq Na/L | 0.42 ± 0.18 a | 0.030 ± 0.009 a |
| 100 meq Na/L | 0.28 ± 0.09 b | 0.400 ± 0.080 b |
| Treatment | N (%) | P (%) | Crude Protein (%) | Digestibility (%) |
|---|---|---|---|---|
| N0 | 0.67 ± 0.08 a | 0.49 ± 0.05 a | 4.18 ± 0.09 a | 79.78 ± 3.12 a |
| N40 | 0.64 ± 0.05 a | 0.58 ± 0.08 a | 4.03 ± 0.08 a | 61.74 ± 5.41 b |
| N80 | 0.98 ± 0.15 b | 0.69 ± 0.07 b | 6.12 ± 0.10 b | 60.58 ± 4.00 b |
| N0 + DSE | 0.77 ± 0.05 a | 0.55 ± 0.04 a | 4.81 ± 0.09 a | 62.22 ± 3.17 b |
| N40 + DSE | 0.72 ± 0.06 a | 0.48 ± 0.07 a | 4.70 ± 0.15 a | 59.66 ± 4.57 b |
| N80 + DSE | 0.92 ± 0.11 b | 0.68 ± 0.12 b | 5.75 ± 0.08 b | 62.12 ± 5.21 b |
Disclaimer/Publisher’s Note: The statements, opinions and data contained in all publications are solely those of the individual author(s) and contributor(s) and not of MDPI and/or the editor(s). MDPI and/or the editor(s) disclaim responsibility for any injury to people or property resulting from any ideas, methods, instructions or products referred to in the content. |
© 2025 by the authors. Licensee MDPI, Basel, Switzerland. This article is an open access article distributed under the terms and conditions of the Creative Commons Attribution (CC BY) license (https://creativecommons.org/licenses/by/4.0/).
Share and Cite
Tobar Gomez, N.E.; Ameijeiras, M.; Benitez, H.E.; Spagnoletti, F.N.; Chiocchio, V.M.; Lavado, R.S. Can the DSE Fungus Exserohilum rostratum Mitigate the Effect of Salinity on the Grass Chloris gayana? Plants 2025, 14, 2537. https://doi.org/10.3390/plants14162537
Tobar Gomez NE, Ameijeiras M, Benitez HE, Spagnoletti FN, Chiocchio VM, Lavado RS. Can the DSE Fungus Exserohilum rostratum Mitigate the Effect of Salinity on the Grass Chloris gayana? Plants. 2025; 14(16):2537. https://doi.org/10.3390/plants14162537
Chicago/Turabian StyleTobar Gomez, Natalia Elizabeth, Marcos Ameijeiras, Hernan E. Benitez, Federico N. Spagnoletti, Viviana M. Chiocchio, and Raúl S. Lavado. 2025. "Can the DSE Fungus Exserohilum rostratum Mitigate the Effect of Salinity on the Grass Chloris gayana?" Plants 14, no. 16: 2537. https://doi.org/10.3390/plants14162537
APA StyleTobar Gomez, N. E., Ameijeiras, M., Benitez, H. E., Spagnoletti, F. N., Chiocchio, V. M., & Lavado, R. S. (2025). Can the DSE Fungus Exserohilum rostratum Mitigate the Effect of Salinity on the Grass Chloris gayana? Plants, 14(16), 2537. https://doi.org/10.3390/plants14162537
